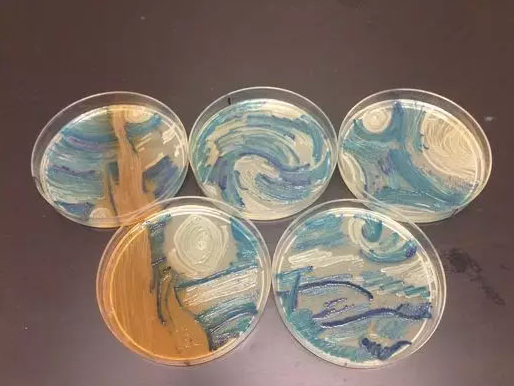

戈皮纳特将这种效应比喻为在桌上放置一排原本并不同步的节拍器,只要条件允许,便会随时间推移逐渐节拍一致。同样地,多个光发射...

此外,研究者还发现,在患者的血液中可以检测到oncomiRs,而这种检测方法与传统的组织活检相比,创伤小、耗时少。并且o...

通过基因编辑技术在iPSCs层面修复HBB CD41/42(-CTTT)突变 iPSCs诱导分化出正常的造血干细胞 ...

但是如果可以拯救我们的牙齿,并且不用往牙齿里面插些奇怪的东西遭罪的话,这倒是一件非常非常非常赞的发明

由于老年人的耳道皮肤薄,较脆弱,所以老年人不宜配耳内式和耳道式。老年人配助听器应该首选耳背式助听器,耳背式助听器相对于其...

Parker介绍说:“有些工程师是从铝制材料中制造东西,而我从细胞中构建。我需要练习,所以我练习构建泵。”不过做机器鱼也...

研究小组认为,如果能够通过这项研究确认摄入NMN是安全和有效的,将来有可能用NMN来预防和治疗伴随衰老发生的疾病。

“我们的发现提示了一种治疗疾病的新手段,那就是生物电疗法,即采用电刺激治疗目前某些主要采用药物疗法的疾病,”参与此次研究...

所以总体而言,并没有一种两全其美的办法能够确保互联网企业获得成功。对于BAT这样的巨头,不差钱自然可以冒一下风险。但对于...

诚然,移动医疗各种模式都有其优缺点。但是必须直面的一个核心问题是,移动医疗最核心的仍然是医疗,而医院是这一过程中又一个核...

“最近各级医院的挂号费调整以后,我们一个正高的挂号费是31块,和星巴克咖啡的价格一样。挂号费不止是挂个号,医生要给他诊断...

除此之外,该公司也希望能开发聚合物支架,这样的话,活细胞可以被添加到支架上以生长出真实的软骨。该公司最终希望能创造出可生...

移动医疗已经开始显露并购整合的趋势,仅两年内获得资本支持的企业本身已经掌握了更多的优质资源,也许移动医疗企业的上市已经不...

移动医疗已经开始显露并购整合的趋势,仅两年内获得资本支持的企业本身已经掌握了更多的优质资源,也许移动医疗企业的上市已经不...

3月3日:四川大学华西医院通过其官网微信发布医院门诊挂号的变更通知。其中,所有专家门诊全部实行预约制和现场挂号制,不再进...
2026-02-06
2026-02-05
2026-02-05
2026-02-04
2026-02-04

